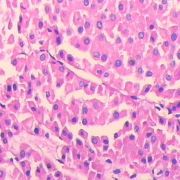

由Admin上传
来自医学百科
本特殊页面展示所有上传的文件。
| 日期 | 名称 | 缩略图 | 尺寸 | 说明 | 版本 |
|---|---|---|---|---|---|
| 2014年1月19日 (日) 00:59 | Bkbvs.jpg (文件) |  |
11 KB | 1 | |
| 2014年1月19日 (日) 00:59 | Bkd83.jpg (文件) |  |
46 KB | 1 | |
| 2014年1月19日 (日) 00:59 | Bk5yp.jpg (文件) |  |
53 KB | 1 | |
| 2014年1月19日 (日) 00:59 | Bk3h5.jpg (文件) |  |
38 KB | 1 | |
| 2014年1月19日 (日) 00:59 | Gmd7qf45.gif (文件) |  |
11 KB | 1 | |
| 2014年1月19日 (日) 00:59 | Bk6rm.jpg (文件) |  |
13 KB | 1 | |
| 2014年1月19日 (日) 00:59 | Bka99.jpg (文件) |  |
74 KB | 1 | |
| 2014年1月19日 (日) 00:58 | Gra3hhdf.jpg (文件) | 5 KB | 1 | ||
| 2014年1月19日 (日) 00:58 | Bkcbd.jpg (文件) |  |
16 KB | 1 | |
| 2014年1月19日 (日) 00:58 | Gkgwz584.gif (文件) |  |
75 KB | 1 | |
| 2014年1月19日 (日) 00:58 | Bkkxh.jpg (文件) |  |
15 KB | 1 | |
| 2014年1月19日 (日) 00:58 | Gmiqe9qr.gif (文件) |  |
20 KB | 1 | |
| 2014年1月19日 (日) 00:58 | Bk3ul.jpg (文件) |  |
11 KB | 1 | |
| 2014年1月19日 (日) 00:58 | Bkg4j.jpg (文件) |  |
7 KB | 1 | |
| 2014年1月19日 (日) 00:58 | Bkemg.jpg (文件) |  |
29 KB | 1 | |
| 2014年1月19日 (日) 00:58 | Gofo0q35.jpg (文件) |  |
7 KB | 1 | |
| 2014年1月19日 (日) 00:58 | Bk5v6.jpg (文件) |  |
13 KB | 1 | |
| 2014年1月19日 (日) 00:58 | Bk0o5.jpg (文件) |  |
60 KB | 1 | |
| 2014年1月19日 (日) 00:58 | Bkh29.jpg (文件) |  |
8 KB | 1 | |
| 2014年1月19日 (日) 00:58 | Bkezg.jpg (文件) | |
43 KB | 1 | |
| 2014年1月19日 (日) 00:57 | Bk491.jpg (文件) |  |
81 KB | 1 | |
| 2014年1月19日 (日) 00:57 | Bkbpb.jpg (文件) |  |
14 KB | 1 | |
| 2014年1月19日 (日) 00:57 | Bknwu.jpg (文件) |  |
6 KB | 1 | |
| 2014年1月19日 (日) 00:57 | Bk39q.jpg (文件) |  |
75 KB | 1 | |
| 2014年1月19日 (日) 00:57 | Gq0r4i00.jpg (文件) |  |
10 KB | 1 | |
| 2014年1月19日 (日) 00:57 | Bk0ut.jpg (文件) |  |
2 KB | 1 | |
| 2014年1月19日 (日) 00:57 | Bkqq9.jpg (文件) |  |
17 KB | 1 | |
| 2014年1月19日 (日) 00:57 | Bkowx.jpg (文件) |  |
29 KB | 1 | |
| 2014年1月19日 (日) 00:57 | Bkbis.jpg (文件) |  |
102 KB | 1 | |
| 2014年1月19日 (日) 00:57 | Gj6xnsca.jpg (文件) |  |
14 KB | 1 | |
| 2014年1月19日 (日) 00:57 | Bkmyf.jpg (文件) |  |
33 KB | 1 | |
| 2014年1月19日 (日) 00:57 | Gmojbx87.jpg (文件) | 4 KB | 1 | ||
| 2014年1月19日 (日) 00:57 | Bkfdo.jpg (文件) |  |
64 KB | 1 | |
| 2014年1月19日 (日) 00:57 | Bka1l.jpg (文件) |  |
14 KB | 1 | |
| 2014年1月19日 (日) 00:57 | Guz0xgar.jpg (文件) |  |
12 KB | 1 | |
| 2014年1月19日 (日) 00:56 | Bkkxr.jpg (文件) |  |
6 KB | 1 | |
| 2014年1月19日 (日) 00:56 | Cang baidu.jpg (文件) |  |
546字节 | 1 | |
| 2014年1月19日 (日) 00:56 | Bk78v.jpg (文件) |  |
30 KB | 1 | |
| 2014年1月19日 (日) 00:56 | Bk4er.jpg (文件) |  |
47 KB | 1 | |
| 2014年1月19日 (日) 00:56 | Gv6f4r93.jpg (文件) |  |
18 KB | 1 | |
| 2014年1月19日 (日) 00:56 | Bk6ar.jpg (文件) |  |
86 KB | 1 | |
| 2014年1月19日 (日) 00:56 | Bkjte.jpg (文件) |  |
44 KB | 1 | |
| 2014年1月19日 (日) 00:56 | Gt85tsyv.jpg (文件) |  |
5 KB | 1 | |
| 2014年1月19日 (日) 00:56 | Bk0v1.jpg (文件) |  |
89 KB | 1 | |
| 2014年1月19日 (日) 00:56 | Gmoe9ppj.jpg (文件) | 9 KB | 1 | ||
| 2014年1月19日 (日) 00:56 | Bkizd.jpg (文件) |  |
29 KB | 1 | |
| 2014年1月19日 (日) 00:56 | Bk9jo.jpg (文件) |  |
3 KB | 1 | |
| 2014年1月19日 (日) 00:56 | Bkhim.jpg (文件) |  |
84 KB | 1 | |
| 2014年1月19日 (日) 00:56 | Gq0q3ape.jpg (文件) |  |
9 KB | 1 | |
| 2014年1月19日 (日) 00:55 | Bkk9s.jpg (文件) |  |
45 KB | 1 |